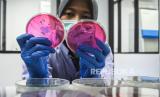

REPUBLIKA.CO.ID, TANGERANG -- Petugas melakukan pengujian kandungan zat kimia pada produk makanan di Laboratorium Kesehatan Daerah (Labkesda) Kota Tangerang, Banten, Jumat (31/5/2024).
Dinas Perindustrian Perdagangan Koperasi dan UKM bersama Dinas Kesehatan Kota Tangerang menyediakan pengujian laboratorium produk olahan makanan untuk memeriksa kandungan mikrobakteri dan kandungan zat kimia pada produk UMKM milik masyarakat Kota Tangerang.